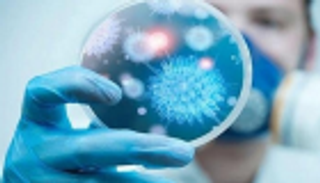

تفشي "كورونا الصين".. الخفافيش والثعابين في قفص الاتهام

الخفافيش يمكن أن تكون المضيف الطبيعي لفيروس كورونا في ووهان، ولكن الوسيط بين الخفافيش والبشر لا يزال غير معروف
ذكر خبراء أن الخفافيش يمكن أن تكون أحد أسباب انتشار فيروس كورونا الجديد، الذي قتل 17 شخصاً حتى الآن في الصين، مؤكدين أن الفيروس الذي يشبه الالتهاب الرئوي تمت الاستهانة به من قبل المجتمع البحثي.
وأشار تقرير لصحيفة "ديلي ستار" البريطانية، إلى أنه ربما تكون الثعابين وحساء الخفافيش الذي يحظى بشعبية كبيرة في الصين من أسباب انتشار فيروس كورونا المميت.
وذكرالتقرير أنه انتشرت مؤخراً صور لأشخاص يتناولون حساء الخفافيش "الفتاك" في إحدى المدن الصينية، وفي أحد المقاطع، يمكن رؤية فتاة تضع خفاشا أسود في فمها بواسطة زوج من عيدان تناول الطعام أثناء جلوسها لتناول العشاء مع الأصدقاء.
وفي بيان حصلت عليه صحيفة "ساوث تشاينا مورنينج بوست" الصينية باللغة الإنجليزية من مجموعة علماء، ذكروا: "يمكن أن تكون الخفافيش المضيف الطبيعي لفيروس كورونا في ووهان.. ولكن الوسيط بين الخفافيش والبشر لا يزال غير معروف".

وفي السياق نفسه، أشار تقرير نشرته شبكة "سي إن إن" الأمريكية إلى أن الثعابين مثل فصيلة كرايت وكوبرا الصينية ربما تكون سببا أيضاً في انتشار فيروس كورونا الجديد.
واستخدم باحثون تحليلاً لرموز البروتين التي يفضلها فيروس كورونا الجديد "nCoV- 2019"، حسبما أطلقت عليه منظمة الصحة العالمية، وقاموا بمقارنتها برموز بروتين أخرى من فيروسات كورونا وجدت في حيوانات مضيفة مختلفة مثل الطيور والثعابين والخفافيش والقنافذ.
واكتشف الباحثون أن الرموز البروتينية في فيروس كورونا الجديد تشبه بصورة كبيرة تلك الموجودة في الثعابين.
ونظراً لأن الثعابين عادة ما تصطاد الخفافيش في البرية، بالإضافة إلى التقارير التي تشير إلى بيع الثعابين في أسواق المأكولات البحرية المحلية في ووهان، تزيد الشكوك حول أن الفيروس انتقل من الفصيلة المضيفة وهي الخفافيش إلى الثعابين ثم إلى البشر قبل هذا الانتشار المرعب للمرض.
وتعد فصيلة ثعابين كرايتي متعددة النطاقات، التي تعرف أيضاً باسم الكرايت التايواني أو الكرايت الصيني، من الأنواع السامة جداً الموجودة في مناطق كثيرة في وسط وجنوب الصين، وجنوب شرقي آسيا.
وأكدت الصين إصابة أكثر من 500 شخص بالفيروس في 22 مقاطعة، ومنذ ذلك الحين أعلنت الحجر الصحي في مدينة ووهان مع استمرار انتشار كورونا المميت.
وظهرت حالات أخرى مصابة بالفيروس القاتل في اليابان وكوريا والولايات المتحدة، ونصحت السلطات الصينية بعدم السفر من وإلى ووهان، حتى إنه تم حظر مرور السيارات.